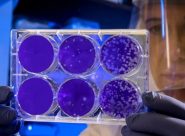

EMERGENZA – Si tratta di una 85enne ricoverata nei giorni scorsi all’Inrca. In arrivo per la città della fisarmoinica mascherine dalla Cina ma due aziende tessili locali hanno riconvertito la linea produttiva per commercializzare le protezioni di sicurezza
0 Commenti